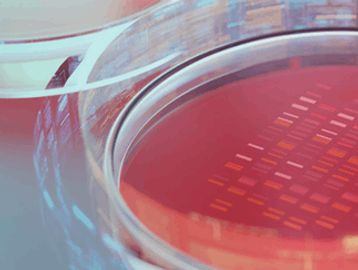

BIOLOGIA CELULAR
MEDIOS DE CULTIVO CELULAR
Los medios basales clásicos como el DMEM,MEM, RPMI, DMEM/F12 contienen varios aminoácidos, vitaminas, carbohidratos, iones de sales inorgánicas y otros nutrientes necesarios para que el crecimiento celular mantenga condiciones óptimas.
Los medios de crecimiento completos contienen los medios basales y otros aditivos necesarios para el crecimiento celular y han sido probados rigurosamente en casi 1000 tipos diferentes de células.
Los suplementos y reactivos permiten a los investigadores personalizar sus medios para adaptarlos a aplicaciones específicas de cultivo celular.
Copyright © 2025 Surgenoma
This website uses cookies.
We use cookies to analyze website traffic and optimize your website experience. By accepting our use of cookies, your data will be aggregated with all other user data.


.png/:/cr=t:1.85%25,l:0%25,w:100%25,h:96.3%25/rs=w:360,h:180,cg:true)